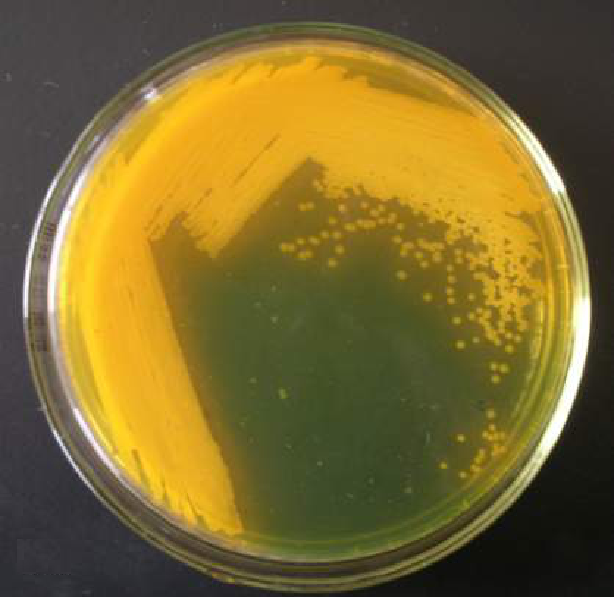

(1)鱼病诊断的基本步骤与方法
将待检测的鱼置于解剖盘上,通过测量尺测量鱼的全长,体长,体高。目检鱼体体表并描述症状。例如体表的鳞片是否完整和有竖鳞现象,是否有出血或充血现象。随后通过解剖刀刮取病鱼体表的黏液放于干净的载玻片上,向载玻片上滴加一滴0.85%的生理盐水,盖上一张盖玻片,轻轻搓压玻片使病料散开,然后将载玻片置于显微镜下观察是否有寄生虫。打开鳃盖,观察鳃片是否完整和有无充血出血现象,是否有污物附着,然后用手术剪剪取部分鳃丝放于干净的载玻片上,在显微镜下观察。将鱼腹剖开,使体腔里的内脏器官露出来。然后观察肝、脾、肾等内脏器官是否有病变现象;同时注意肠壁上、脂肪组织、肝、胆囊、脾、鳔等有无肉眼可见的病原体。

病鱼的解剖观察
(2)病原菌的分离、纯化与培养
将病鱼放在解剖盘上,用注射器从鱼腹腔中吸取腹水,加到准备好的1.5mL离心管中。在超净工作台中,用酒精棉球擦拭双手,待酒精挥发后点燃酒精灯。用外焰对接种环进行消毒,冷却后蘸取腹水,然后在平板上Z型划线,然后再用酒精灯的外焰对接种环进行消毒,转动平板90度,接在上一次划线的末尾再次Z型划线,重复三次。
病原菌的划线分离培养
将平板以有培养基的一面向下放入37℃恒温培养箱中,30min后将平板翻面继续培养,24h后观察结果,此时的平板应该能看到明显菌落,并且有单菌落出现。将培养好的平板放在超净工作台上,用酒精棉球擦拭双手,待酒精挥发后点燃酒精灯。将LB液体培养基瓶口移至火焰上旋转烧灼,拔掉瓶塞,用外焰对接种环进行消毒,冷却后挑取取单菌落加入液体培养基中,瓶口通过火焰,塞好瓶塞,将接种环灭菌后放下。将液体培养基放于37℃恒温摇床中培养。培养24h后,应该能观察到培养基由澄清变为浑浊。
(3)细菌分子生物学鉴定



PCR过程
细菌DNA提取。在超净工作台中,用酒精棉球擦拭双手,待酒精挥发后点燃酒精灯。将以培养好的菌液瓶口移至火焰上旋转烧灼,拔掉瓶塞,用移液枪吸取菌液置于1.5mL离心管中。在实验台上,按照细菌DNA提取试剂盒的说明书的步骤,使用离心机和移液枪提取离心管中菌液的DNA。在天平中称量0.4g的琼脂糖置于三角瓶中,再加入40mL的TAE缓冲液,放入微波炉反复加热2-3次至琼脂糖完全溶解。待三角瓶稍稍冷却,至不烫手时加入1μL的核酸染料,将液体轻轻倒入胶槽内,并插好梳子。20min左右胶即可凝固。吸取5μL之前提取的DNA和1μL的6×Loading Buffer,充分混匀后滴加到相应的核酸胶的胶孔中,并在相邻的胶孔中加入5μL的DNAMaker,把电泳仪调成电压120V,电流50-60mA,时间30min。电泳结束后的胶置于凝胶成像系统中观看结果。
细菌DNA的PCR扩增。在实验台上用移液器将PCR所需的试剂和样品加至200μL离心管中。将加样完成的离心管置于PCR仪中,接下来设定PCR的程序,PCR原理如图5-3所示。在天平中称量0.4g的琼脂糖置于三角瓶中,再加入40mL的TAE缓冲液,放入微波炉反复加热2-3次至琼脂糖完全溶解。待三角瓶稍稍冷却,至不烫手时加入1μL的核酸染料,将液体轻轻倒入胶槽内,并插好梳子。20min左右胶即可凝固。吸取5μL之前提取的DNA和1μL的6×Loading Buffer,充分混匀后滴加到相应的核酸胶的胶孔中,并在相邻的胶孔中加入5μL的DNA Maker,把电泳仪调成电压120V,电流50-60mA,时间30min。电泳结束后的胶置于凝胶成像系统中观看结果。
16srDNA鉴定。将细菌DNA的PCR产物送测序,返回测序结果以后,在计算机上,按照步骤应用BLAST对测序结果进行细菌16srDNA鉴定。
(4)病原菌的回归感染实验

病原菌的回归感染
采用微量进样器吸取50μL病原菌,在解剖盘上对鱼进行腹腔注射,并剪鳍条对自己注射的鱼进行标记,然后将鱼置于鱼缸中。在鱼缸中进行饲养实验,定时观察实验动物的发病和死亡情况。
(5)鱼类寄生虫病诊断

寄生虫诊断
病鱼放置于解剖盘上,用解剖刀刮取病鱼体表的黏液放于干净的载玻片上,然后用手术剪剪取部分鳃丝放于干净的载玻片上,向已经放置样品的载玻片上滴加一滴0.85%的生理盐水,盖上一张盖玻片,轻轻搓压玻片使病料散开,然后将载玻片置于显微镜下检查。如果有寄生虫,首先根据外形特征鉴定所检查的寄生虫的种属,然后分辨其种类并计数一个视野内该种类寄生虫的数量。
(6)药物对鱼类的急性毒性实验
向不同药物浓度试验组的鱼缸中加入确定体积的水体,根据试验所需的终浓度加入不同体积的药物母液。从鱼群中随机挑选体型相近的鱼并迅速放入各试验组的鱼缸中。在实验的第一天,于试验开始后1、3、6、12和24h观察试验鱼的状态。之后至少每隔24h观察一次,记录死亡数。如果没有任何肉眼可见的运动,如鳃的扇动、碰触尾柄后无反应等,即可判断该鱼已死亡。观察并记录死鱼数目后,将死鱼从容器中取出。根据记录结果,在计算机上运用SPSS软件计算试验药物的24-96h LC50值。

鱼类急性毒性实验
CopyRight 2015 All rights reserved. 西北农林科技大学 动科学院 版权所有
地址:中国 • 陕西 • 杨凌 邮编:712100
主管领导: 杨小军 网管员: 刘瑞芳